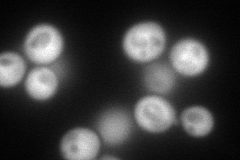
YNL259C
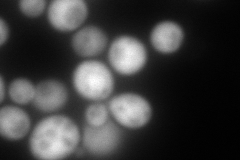
YNL259C
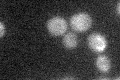
YNL259C

View description
Cytosolic copper metallochaperone that transports copper to the secretory vesicle copper transporter Ccc2p for eventual insertion into Fet3p, which is a multicopper oxidase required for high-affinity iron uptake
Localization:
Intensity:
Fold change:
Significance:
-
C’ GFP library in SD

below threshold14.67 -
N' NOP1pr-GFP in SD
cytosol188.903 -
N' TEF2pr-mCherry in SD
cytosol364.526 -
N' NATIVEpr-GFP in SD

cytosol48.3882 -
N' TEF2pr-VC and Cyto-VN in SD

#N/A0 -
C’ GFP library in SD+DTT

cytosol17.551.19No -
C’ GFP library in SD+H2O2
cytosol16.621.13No -
C’ GFP library in Starvation Media

cytosol15.271.04No -
C’ GFP library on the background of Pup2-DaMP

below threshold -
C’ GFP library on the background of CCT mutant

below threshold14.03130.956258No
